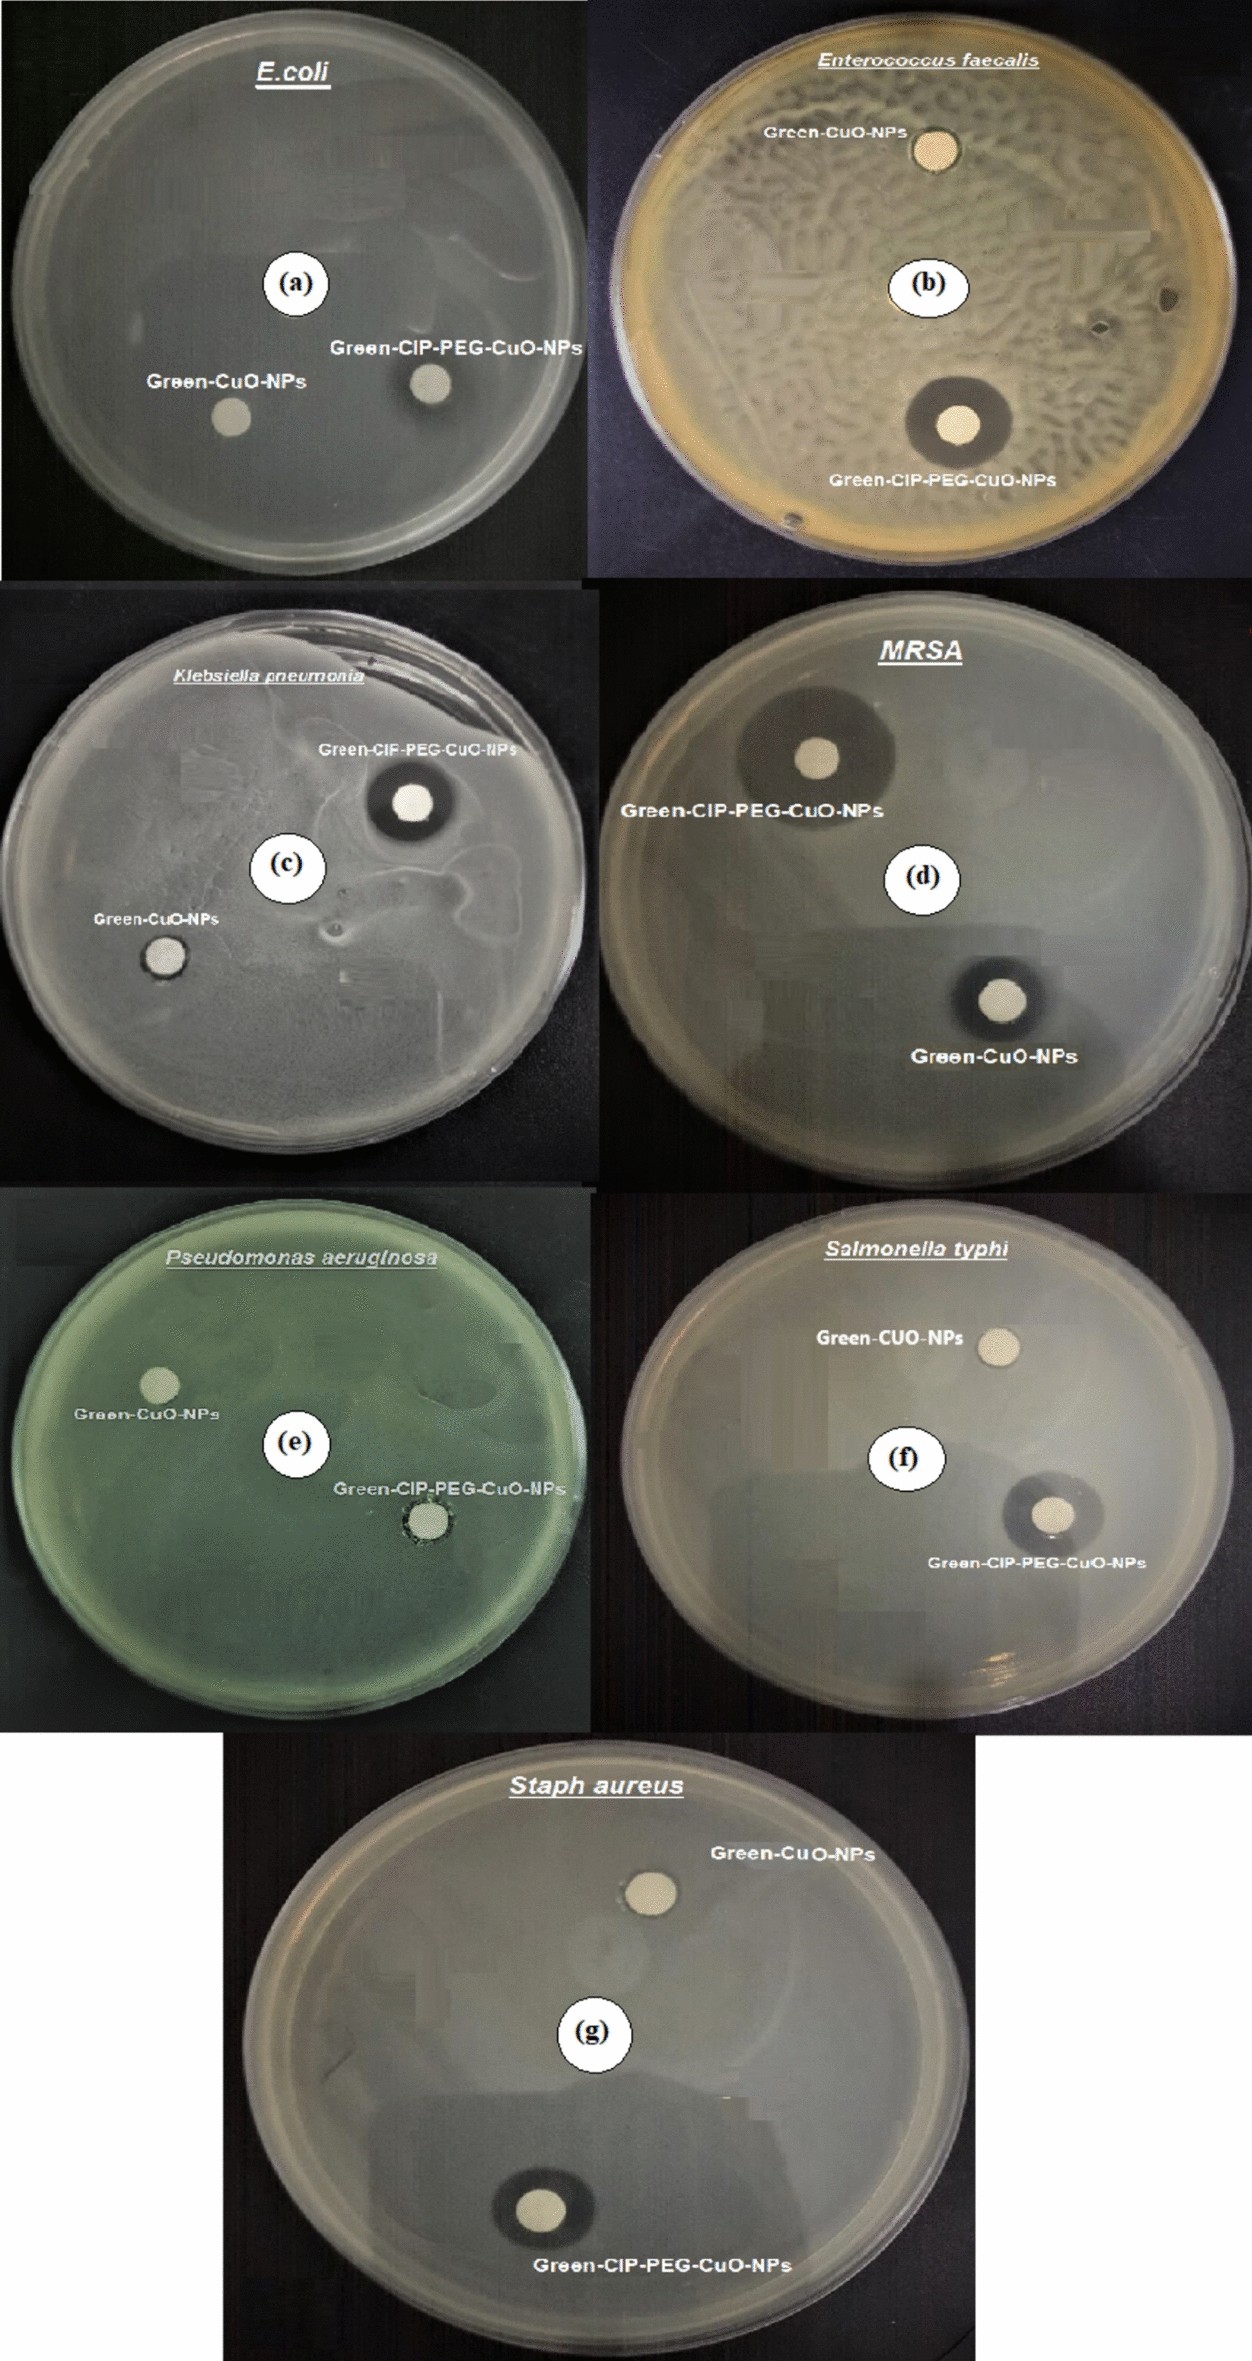
Fig. 4

Fig. 4

Sensitivity patterns of green synthesized CuO- NPs/nano-formulations against bacterial strains, (a) E. coli, (b) Enterococcus faecalis, (c) Klebsiella pneumonia, (d) MRSA, (e) Pseudomonas aeruginosa, (f) Salmonella typhi, (g) S. aureus.
Sensitivity patterns of green synthesized CuO- NPs/nano-formulations against bacterial strains, (a) E. coli, (b) Enterococcus faecalis, (c) Klebsiella pneumonia, (d) MRSA, (e) Pseudomonas aeruginosa, (f) Salmonella typhi, (g) S. aureus.